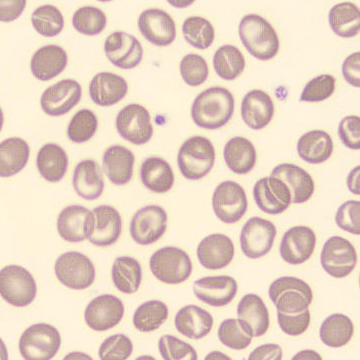

RET - SAO
FSC
SFL
Erythrozyten
Retikulozyten
RBC-Fragmente
Die Erythrozytenpopulation ist entlang der y-Achse gestreckt und gut abgegrenzt; ein diffuses Muster innerhalb der Erythrozytenpopulation ist nicht vorhanden . Daraus ist ersichtlich, dass die Erythrozyten von unterschiedlicher Größe sind, aber nicht unregelmäßig geformt sind, wie z. B. die Fragmentozyten.
Die Form dieser Population ist ziemlich typisch für die Hämoglobinopathie Südostasiatische Ovalozytose. In diesem Fall sind im Ausstrich Knizozyten zu sehen.
Morfologie